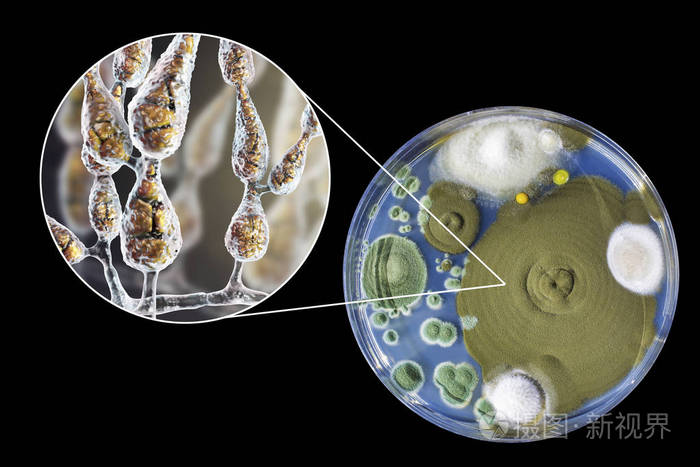
交替链格孢菌在营养培养基上的菌落图解和照片

交链孢

交链胞霉
图片尺寸665x1183
交链孢霉属
图片尺寸220x213
交替链格孢菌在营养培养基上的菌落图解和照片
图片尺寸480x320
交替链格孢菌在营养培养基上的菌落图解和照片
图片尺寸700x467
柑橘褐斑病来袭,种了这些易感品种的,请抓紧防范!
图片尺寸640x433
茄子(交链孢)果腐病
图片尺寸800x600
链格孢霉,过敏性真菌照片
图片尺寸600x300
臭氧处理对交链孢菌生长及其毒素积累的抑制作用
图片尺寸500x425
交替链格孢菌在营养培养基上的菌落图解和照片
图片尺寸480x320
室里还会还有多种多样的霉菌,例如镰刀霉属,头孢霉属,交链孢霉属等等
图片尺寸281x269
交链孢酚
图片尺寸300x300
641-38-3 交链孢酚
图片尺寸300x300
链格孢
图片尺寸633x442
交链孢霉属|1|5
图片尺寸220x165
互隔交链孢霉(斜面)
图片尺寸368x217
茄子交链孢果腐病
图片尺寸440x503
交链孢霉曲霉曲霉是发酵工业和食品工业的重要菌种,已被利用的近60种
图片尺寸1080x1223
异互隔交链孢霉素
图片尺寸600x600
陈慧敏 多主棒孢霉
图片尺寸1440x1080
吸入性过敏原大全过敏性鼻炎反反复复原来是它们在捣蛋
图片尺寸640x379